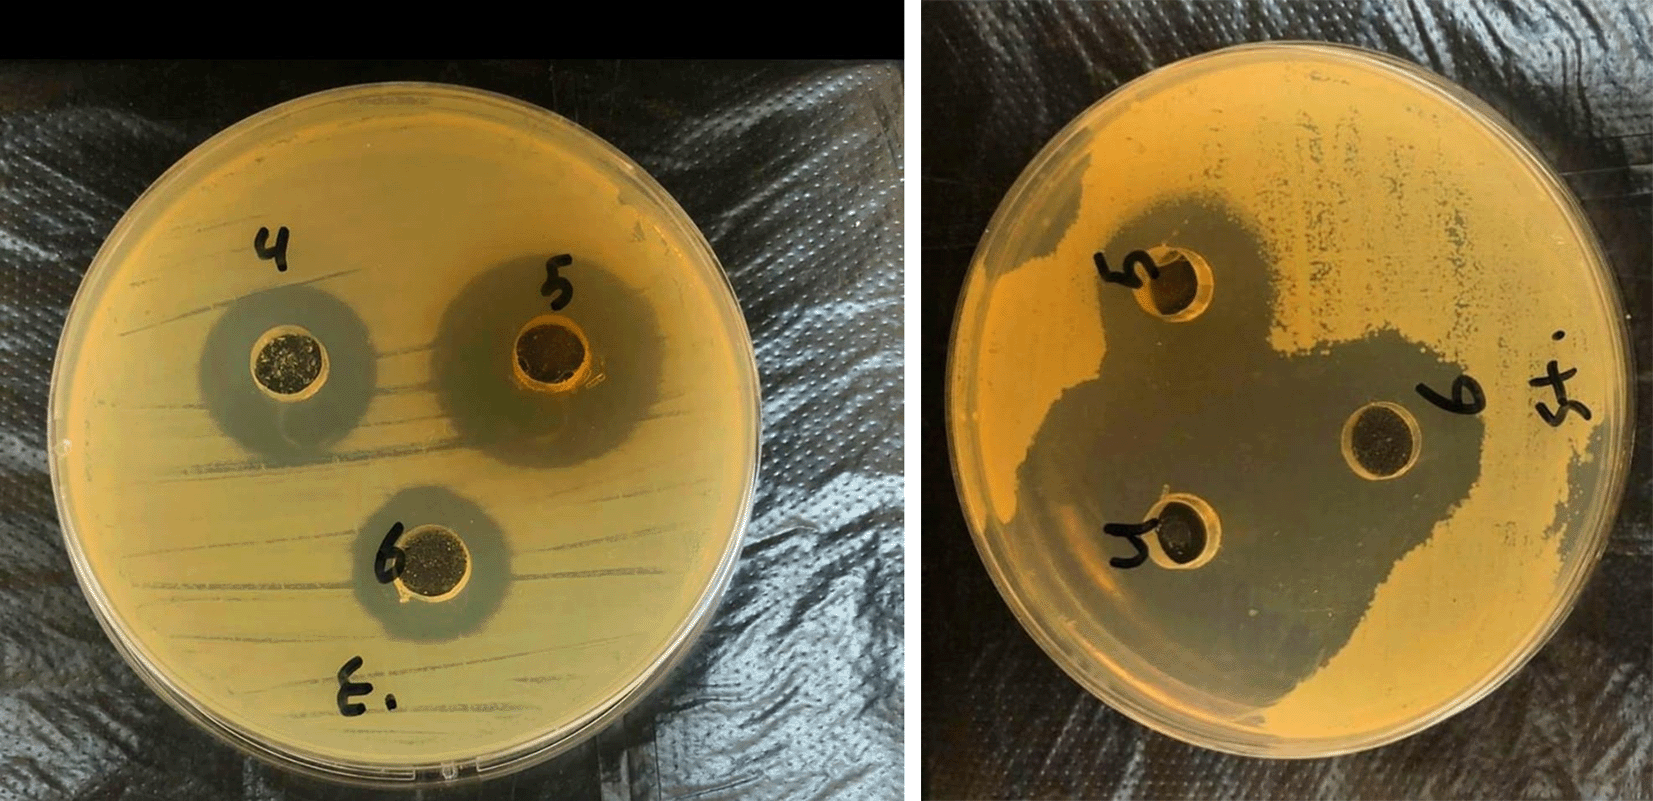
b212586d-88e3-41f6-ac66-811472231243_figure3.gif

Keywords
Biosynthesis, Silver oxide, Nanoparticles, Boswellia caretter
This article is included in the Nanoscience & Nanotechnology gateway.
This article is included in the Fallujah Multidisciplinary Science and Innovation gateway.
Frankincense (Boswellia carterii) is a natural resin rich in biologically active compounds, especially boswellic acids, which contribute to its anti-inflammatory and therapeutic properties. Plant extracts have become valuable in the green synthesis of metal nanoparticles because they act as safe, low-cost and stabilizing agents, offering an environmentally friendly alternative to conventional chemical methods.
In this study, silver oxide nanoparticles were prepared using an aqueous extract of Boswellia carterii. The extract was obtained by dissolving 1 g of crude resin in 100 mL of deionized water, heating at 50°C, and filtering to remove insoluble material. A 1 mM solution of silver nitrate was prepared by dissolving 0.015 g of AgNO₃ in 100 mL of water. The silver solution was added gradually to the warm extract under continuous stirring, and the mixture was heated up to 140°C for 50 minutes until a dark brown color appeared, indicating nanoparticle formation. The product was then centrifuged, washed several times, and left to dry. Structural characterization was carried out using X-ray diffraction, and the crystallite size was calculated using the Scherrer equation. Particle morphology was examined by scanning electron microscopy.
The antibacterial activity of the synthesized nanoparticles was evaluated against Pseudomonas aeruginosa and Streptococcus species at concentrations of 60%, 80%, and 100%. The XRD results confirmed the formation of silver oxide with an orthorhombic crystalline structure corresponding to standard reference data, with an average crystallite size of 80.6 nm. SEM images revealed that the particles were relatively uniform in distribution, with diameters ranging from 55.84 to 82.17 nm. Antibacterial testing showed clear inhibition zones measuring between 14.5 and 23 mm for both bacterial strains, with a stronger effect observed against Streptococcus.
These findings demonstrate that Boswellia carterii extract can serve as an effective natural agent for the green synthesis of silver oxide nanoparticles, producing particles with suitable structural characteristics and notable antibacterial activity.
Biosynthesis, Silver oxide, Nanoparticles, Boswellia caretter
Frankincense, an aromatic resin, is extracted from dried liquids (also known as olibanum), and is extracted from Boswellia trees. Boswellic acids (BAs) extracted from Boswellia trees are essential in in vivo and in vitro studies of their bioactive components. Boswellic acids provide the high degree of anti-inflammatory properties of frankincense, due to its biomechanical and molecular properties. Due to their lipophilic nature, their ability to bind or dissolve liquids or fats reduces their solubility in aqueous environments, as well as their bioavailability. Frankincense also contains a group of pentacyclic terpenic acids known as lipoic acids.1,2
Plant exudates have been used as capping and reducing agents in the green synthesis of silver, gold and platinum nanoparticles.3–5 These natural polymers stabilize the nanoparticles, which are non-toxic to cells and potentially useful for molecular imaging, biomedical diagnosis, and safe drug delivery. Silver nanocomplexes are promising materials and can be used as coating materials in food packaging and biomedical engineering, where biocompatibility and antibacterial activity are required.6,7 The regulation of the mean particle size and the distribution of particle size during synthesis of the silver nanoparticle with hydroxyl functionalized water soluble polymers is also facilitated.8
Gum olibanum is chosen as a biopolymer for silver nanoparticles synthesis because it is available, nontoxic and low cost and has medicinal applicability. In this context, we have established an easy, biosynthetic procedure for the synthesis of silver nanoparticles using gum olibanum, a natural plant polymer that is both renewable and biodegradable, as the stabilizing and reducing agent. The aim of the present work was the synthesis and characterization of silver nanoparticles. For potential biological applications, we have also shown antibacterial activity on the produced nanoparticles towards the Gram-positive and Gram-negative bacteria.
One of the more frequent causes of infections is Pseudomonas aeruginosa in a medical facility. These infections are linked to substantial morbidity and medical costs, particularly when It takes longer to receive the right antibiotic treatment. The selection of antibiotics It is difficult to treat patients with P. aeruginosa infections because of the infection’s innate resistance to numerous commercially available capable of antibiotics. Multidrug-resistant strains are prevalent, and often require treatment with novel or “last resort” agents.9
Gram-positive, spherical, non-motile, and spore-forming streptococcus bacteria are frequently seen in chains. They are categorized as beta-hemolytic (full lysis, like S. pyogenes), alpha-hemolytic (partial lysis, like S. pneumoniae and the viridans group), and gamma-hemolytic (non-lysis, like some Enterococcus) based on their capacity to lyse blood on blood agar. They can also be categorized into groups (A, B, C, etc.) using the Lancefield approach.
The most significant species are S. pneumoniae, which causes pneumonia, otitis media, meningitis, and sinusitis; S. pyogenes (group A), which causes pharyngitis, scarlet fever, skin infections, rheumatic fever, and glomerulonephritis; S. agalactiae (group B), which causes infections in neonates; and viridans streptococci, which are naturally found in the mouth and can cause endocarditis. Culture and assays such the optochin test (for S. pneumoniae), CAMP test (for group B), and bacitracin susceptibility (for group A) are used to make the diagnosis. Although penicillin or its derivatives constitute the mainstay of treatment, some species—especially S. pneumoniae—may exhibit resistance, necessitating the use of cephalosporins or macrolides as alternatives.10
The novelty of this research is achieved through the environmentally friendly greening of silver oxide nanoparticles using Boswellia carterii extract as a natural and safe reducing agent. These particles were tested for their antibacterial activity against Pseudomonas aeruginosa and Streptococcus, aureus bacteria, demonstrating promising antibacterial results, suggesting their potential as safe alternatives to conventional antibiotics.
This research aims to prepare silver oxide nanoparticles using Boswellia carterii extract in an environmentally friendly manner, and study their antibacterial activity against Pseudomonas aeruginosa and Streptococcus.
Silver oxide nanoparticles were prepared using a 1 mM Boswellia caretterii extract. 0.015 g of silver nitrate (AgNO3) was dissolved in 100 ml of deionized water to obtain a 1 mM solution. The Boswellia caretterii extract was prepared by dissolving 1 g of crude Boswellia caretterii in 100 ml of deionized water. The mixture was then heated to 50°C for 10 min using a magnetic stirrer to facilitate the extraction of the active compounds. The solution was then filtered through filter paper to obtain the pure Boswellia caretterii extract. The resulting extract was placed on a magnetic stirrer and heated to 50°C. The silver nitrate solution was then gradually added to the extract under continuous stirring. The temperature of the mixture was gradually increased, taking care not to exceed 140°C, for 50 min until the solution turned dark brown, indicating the synthesis of silver oxide nanoparticles. After the reaction was complete, the resulting solution was cooled and then separated using centrifugation at 10,000 rpm for 15 min. The resulting precipitate was rinsed with deionized water several times to remove residual contaminants and then allowed to dry at room temperature.11,12
Particle size and crystallite size were calculated from the results of scanning electron microscope (SEM) and x-Ray diffraction respectively. The dimensions of the nanocrystals are calculated using the Scherrer equation ( ), where X-ray diffraction (XRD) data are used by determining the apex angle and measuring its width at half height (FWHM). The tests were done in thin film laboratory at University of Tehran.
This research studies the resulting patterns through X-ray diffraction testing, and determined the particle size through SEM testing. The effect of the produced silver oxide nanoparticles on two types of bacteria, namely Psedumonas and Striptococci, was also evaluated.
The result of the X-ray examination presents the diffraction pattern as shown in Figure 1. After comparison with the standard cards, it was found that the produced material, which is silver oxide, has a polycrystalline structure and is related to diffraction from the crystal planes of the orthorhombic system, which was determined through the standard values (JCPDS 84-1547) as listed in Table 1.
The average crystal size of silver oxide nanocrystals was also calculated, and the average crystal size was 80.6 nm.
Figure 2 shows the scanning electron microscope image at 60.00 kx and 80.00 kx magnifications. From Figure 2a, which is obtained using 60.00 kx magnification, we notice that the silver oxide nanoparticles are relatively homogeneously distributed in most areas.
From Figure 2b which is obtained using 80.00 kx magnification, which shows fine details, allowing us to determine the diameters of these particles, we notice that the diameters of the nanoparticles range between 55.84 and 82.17 nm. These sizes are suitable for medical and environmental applications. Nanoparticles of this size have a large surface area relative to their volume, which increases their interaction with other molecules, allowing them to easily bind drugs or biosensors. It also increases their ability to absorb contaminants or catalyze chemical reactions. Furthermore, particles smaller than ~100 nanometers can easily enter cells without being quickly eliminated from the body, which is important for drug delivery.13
After studying the structural properties of silver oxide nanoparticles produced by the Green Synthesis method, the effect of these manufactured particles on two types of bacteria, namely Pseudomonas aeruginosa and Streptococci, was studied.
Different concentrations were used for the prepared samples, and these concentrations were 60%, 80%, and 100%. When using all the mentioned concentrations separately, an antibacterial effect against Pseudomonas aeruginosa and Streptococci was appeared. The diameter of the inhibition zone ranged between 14.5 mm and 23 mm, as shown in Figure 3 using of samples prepared from silver oxide nanoparticles against Pseudomonas aeruginosa bacteria. The diameters of the inhibition zones ranged from 14.5 mm at a concentration of 60% to 18 mm at a concentration of 100%, as shown in Table 2. This means diameter of inhibition zone increases with increasing concentration.14,15
| Sol. Concentration % | Diameter (mm) pseudomonas | Diameter (mm) streptococci |
|---|---|---|
| 100% | 18 | 23 |
| 80% | 17 | 19 |
| 60% | 14.5 | 17.5 |
While when using samples prepared from silver oxide nanoparticles against Streptococcus bacteria, the diameters of the inhibition zones ranged between 17.5 mm at a concentration of 60% and up to 23 mm at a concentration of 100%, as shown in Table 2. From above presented results, we conclude the high effectiveness of silver oxide nanoparticles against highly virulent bacteria. This result is better than the results obtained by Gheni and Odaa.16
The optical and structural properties of nanomaterials undergo substantial modifications as a result of their enormous surface area-to-volume ratio rise, which can approach millions of times. The majority of bacterial cell membranes have nanoscale holes or pores. Nanostructures must successfully penetrate and stabilize these membranes in order to affect bacterial growth and the essential processes of the cells.17,18
The mechanism of action of nanoparticles, which researchers employ in a variety of ways to stop bacterial development, is essentially the same: the particles’ positive charges interact with the negative charges on the surface of the bacterial cell. As a consequence of this contact, particles accumulate on the cell membrane, changing structure and properties of the membrane. This cripples the cell, and it becomes unable to perform life-sustaining functions such as respiration, permeability and electron transport.19–21
The way nanoparticles work, which researchers have harnessed in a range of techniques to halt bacterial growth, is fundamentally the same: Positive charges in the particles interact with negative charges on the surface of the bacterial cell. A particle can be deposited on the outer part of the cell membrane by this contact and influence the chemical and physical property of the membrane. This ruins the functionality of the cell, inhibiting vital activities such as respiration, permeability, and electron transport.22,23
Studies indicate that nanoparticles with diameters ranging from 1 to 100 nanometers possess unique physical and chemical properties, such as increased surface area to volume ratio, which enhances their interaction with other molecules. This allows them to easily interact with drugs or biosensors and increases their ability to absorb contaminants or catalyze chemical reactions. Furthermore, particles smaller than 100 nanometers can easily enter cells without being rapidly eliminated from the body, which is important for drug delivery.24,25
The novelty of this research lies in its adoption of an environmentally friendly method for preparing silver oxide nanoparticles using Boswellia carterii extract as a natural reducing and stabilizing agent. This method is safe and economical compared to traditional chemical methods. The use of this plant to produce silver oxide nanoparticles represents a new step in this field, as it has not previously been widely employed for this purpose. The importance of the study also lies in testing the effectiveness of these nanoparticles against two types of medically and clinically important bacteria, Pseudomonas aeruginosa (Gram-negative) and Streptococcus, (Gram-positive), which are known for their resistance to antibiotics. The results showed a promising ability of these particles to inhibit bacterial growth, suggesting their potential use as alternatives or complements to traditional antibiotics.
This study successfully produced silver oxide nanoparticles bioactively using Boswellia caretteri extract. The particle sizes ranged between 55.84 and 82.17 nm, with an average size of 80.6 nm. The results demonstrated the clear effectiveness of these particles against the bacteria under study, with their effect on Streptococcus bacteria being higher than on Pseudomonas aeruginosa bacteria. These results suggest the potential for relying on environmentally friendly bio-based methods to produce biocompatible nanomaterials that can be used in medical applications. Further studies are recommended to more precisely elucidate the mechanism of action and ensure their safety before clinical use.
No datasets were created or analyzed during the current study. All data relied upon in this article are derived from previously published studies, which have been cited and included in the references.
| Views | Downloads | |
|---|---|---|
| F1000Research | - | - |
|
PubMed Central
Data from PMC are received and updated monthly.
|
- | - |
Provide sufficient details of any financial or non-financial competing interests to enable users to assess whether your comments might lead a reasonable person to question your impartiality. Consider the following examples, but note that this is not an exhaustive list:
Sign up for content alerts and receive a weekly or monthly email with all newly published articles
Already registered? Sign in
The email address should be the one you originally registered with F1000.
You registered with F1000 via Google, so we cannot reset your password.
To sign in, please click here.
If you still need help with your Google account password, please click here.
You registered with F1000 via Facebook, so we cannot reset your password.
To sign in, please click here.
If you still need help with your Facebook account password, please click here.
If your email address is registered with us, we will email you instructions to reset your password.
If you think you should have received this email but it has not arrived, please check your spam filters and/or contact for further assistance.
Comments on this article Comments (0)